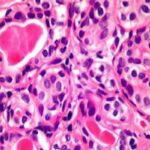

Karim Ben Becher, ambassadeur de Tunisie au Cameroun, a été reçu en audience, jeudi 1er février 2024, par le ministre de l’Economie, de la Planification et de l’Aménagement du Territoire, Alamine OUSMANE MEY, pour présenter ses lettres d’adieu.
Selon le site dudit ministère (minepat.gov.cm), les deux responsables se sont félicités de l’excellence des relations qu’entretiennent la Tunisie et le Cameroun, et ce depuis une soixantaine d’années.
Le diplomate tunisien « s’est par exemple réjouit de la qualité des échanges entre les milieux d’affaires des deux pays, qui se traduisent par la densification et la diversification des échanges commerciaux ». D’ailleurs, la balance commerciale a connu une progression de 25% au cours des trois dernières années, sachant que le Cameroun est le premier partenaire commercial de la Tunisie en Afrique centrale.
Karim Ben Becher a également parlé de l’importance du transport aérien, annonçant que « des diligences sont actuellement menées par le gouvernement tunisien pour desservir le Cameroun via la compagnie Tunisair ».
Toujours selon la même source, le Covid-19 et la guerre en Ukraine ont fortement impacté la dépendance du Cameroun aux importations des produits agroalimentaires de l’Occident, offrant ainsi une opportunité d’échanges commerciaux entre la Tunisie et le Cameroun, avec la mise en œuvre de la Zone de libre-échange continentale africaine (ZLECAf). « Le Cameroun a d’ailleurs été honoré de figurer parmi les sept premiers pays à recevoir les premières cargaisons tunisiennes sous le régime de la ZLECAf ».
De son côté, Alamine Ousmane Mey, a évoqué la complémentarité des économies entre le Cameroun et la Tunisie, assurant que «… les gouvernements des deux pays gagneraient à dynamiser davantage ces échanges déjà perceptibles dans les filières bois et les matières grasses d’origine végétale ».
Il est également question de la nécessité, pour le Cameroun, de tirer profit de l’expérience tunisienne qui est davantage proche des réalités camerounaises.
Les deux hommes ont, enfin, parlé de la préparation des assises de la 11ème session de la Grande commission mixte de coopération Cameroun-Tunisie, prévue au Cameroun au cours de cette année 2024.